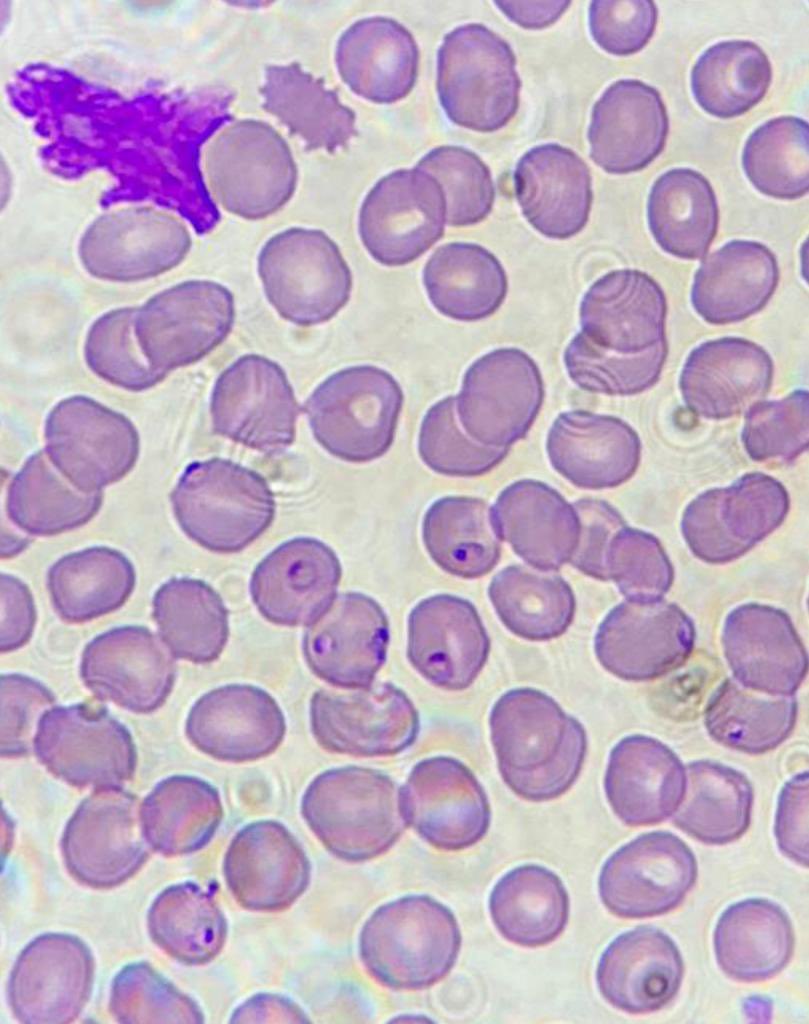
Daniel García tweet media

Daniel García retweetledi

Me hace mucha ilusión compartir que somos finalistas en #INNOVAH2025 🙌
Con Código Rojo queremos transformar la forma en la que los médicos acceden a conocimiento y formación, usando #IA como aliada
¿Nos echas una mano con un ❤️ y un RT?
@NovartisSpain @SETH__Oficial @sehh_es
GIF
Español